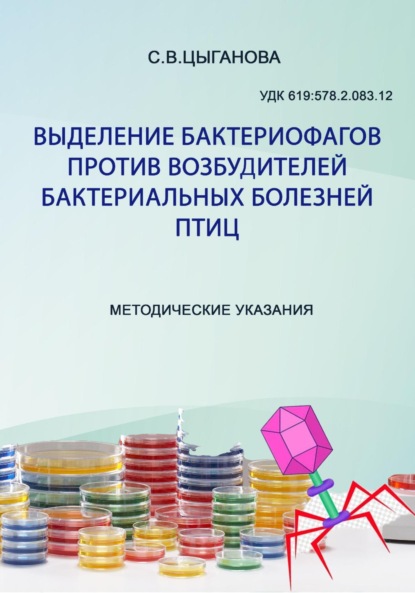
img

Сергей Анатольевич Бабичев - Медицинская микробиология, иммунология и вирусология

- Литрес:4.6
- Livelib:4.6
Учебник состоит из семи частей. Часть первая – «Общая микробиология» – содержит сведения о морфологии и физиологии бактерий. Часть вторая посвящена генетике бактерий. В части третьей – «Микрофлора биосферы» – рассматривается микрофлора окружающей среды, ее роль в круговороте веществ в природе, а также микрофлора человека и ее значение. Часть четвертая – «Учение об инфекции» – посвящена патогенным свойствам микроорганизмов, их роли в инфекционном процессе, а также содержит сведения об антибиотиках и механизмах их действия. Часть пятая – «Учение об иммунитете» – содержит современные представления об иммунитете. В шестой части – «Вирусы и вызываемые ими заболевания» – представлены сведения об основных биологических свойствах вирусов и о тех заболеваниях, которые они вызывают. Часть седьмая – «Частная медицинская микробиология» – содержит сведения о морфологии, физиологии, патогенных свойствах возбудителей многих инфекционных заболеваний, а также о современных методах их диагностики, специфической профилактики и терапии. Учебник предназначен для студентов, аспирантов и преподавателей высших медицинских учебных заведений, университетов, микробиологов всех специальностей и практических врачей. 5-е издание, исправленное и дополненное